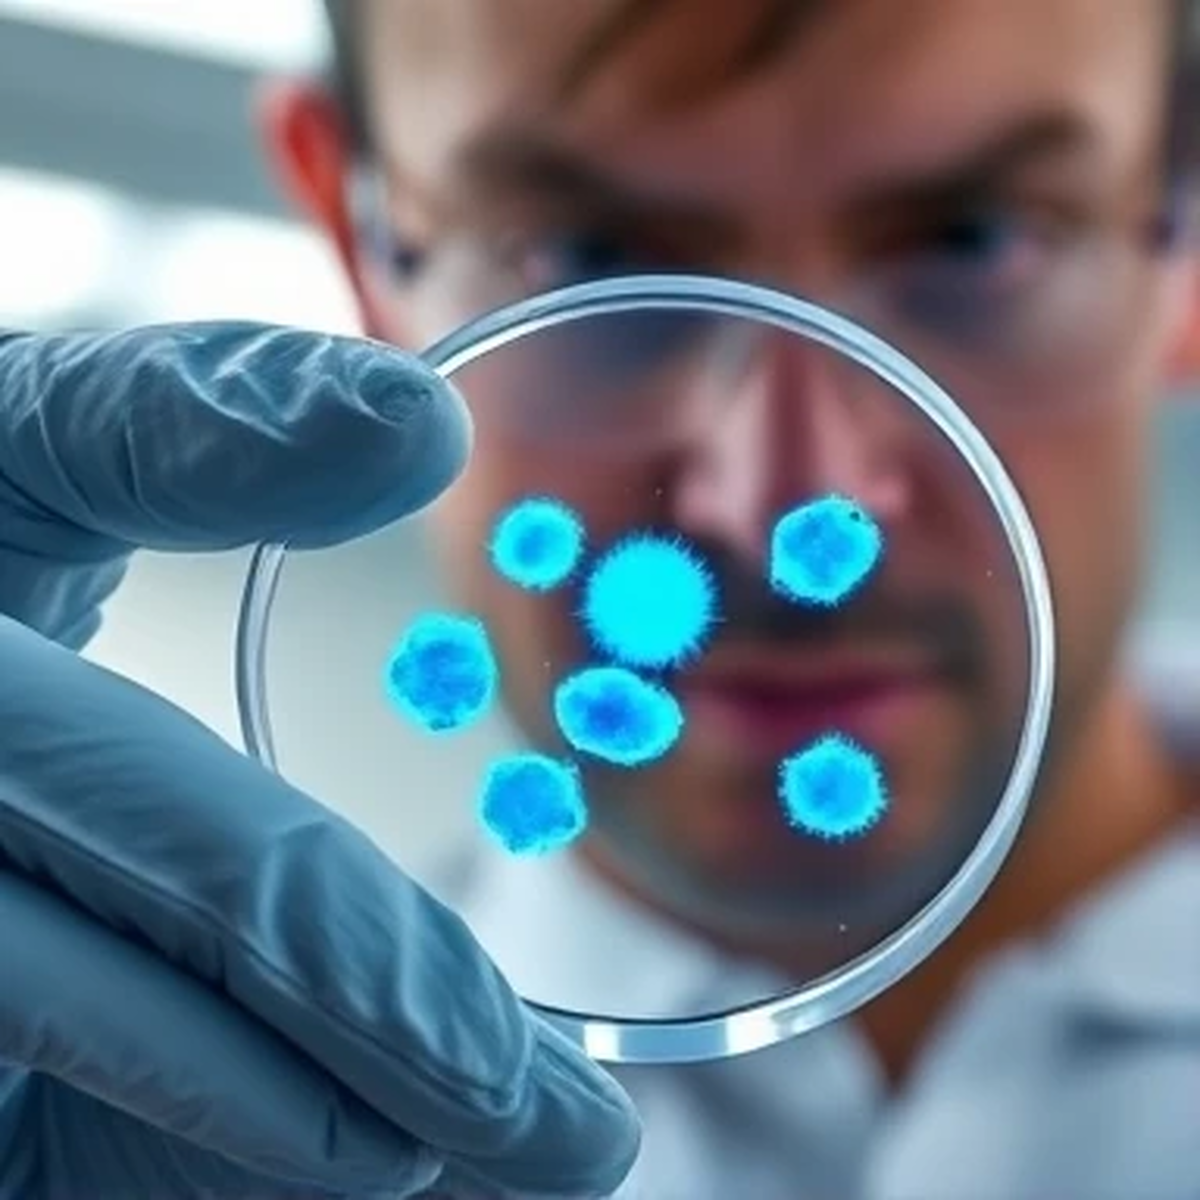

به گزارش پایگاه خبری دانا، گروه دانش و فناوری:
برای قرنها، پیری یک فرآیند اجتنابناپذیر و طبیعی تلقی میشد. اما امروز، دیدگاه علم به طور بنیادین در حال تغییر است. شاخه جدیدی از علم به نام «ژرونتولوژی» (پیریشناسی) پیری را نه یک تقدیر، بلکه یک بیماری مزمن و قابل درمان میداند که ناشی از تجمع آسیبهای مولکولی و سلولی در طول زمان است. این تغییر پارادایم، حاصل پیشرفتهای خیرهکننده در درک ما از زیستشناسی بنیادی پیری است. دانشمندان اکنون به «هالمارکهای پیری» دست یافتهاند: مجموعهای از مکانیسمهای مشترک که در همه موجودات، از کرمها تا انسانها، باعث زوال عملکرد و افزایش آسیبپذیری در برابر بیماری میشوند. این نشانگرها شامل کوتاه شدن تلومرها (کلاهکهای محافظ انتهای کروموزوم)، ناتوانی سلولهای پیر در تکثیر (پیرشدگی سلولی یا سِنِسِنس)، اختلال در عملکرد میتوکندری (نیروگاه سلول)، و تغییر در اپیژنوم (دستورالعملهای روشن و خاموش کردن ژنها) هستند.
هدف جدید علم، مداخله در این مکانیسمها برای به تاخیر انداختن، متوقف کردن یا حتی معکوس کردن روند پیری است. یکی از امیدوارکنندهترین حوزهها، پژوهش بر روی «سِنولیتیکها» است. این داروها به طور خاص سلولهای پیر (زاندا) را که دیگر تقسیم نمیشوند اما با ترشح مواد التهابی، محیط اطراف خود را مسموم میکنند، شناسایی و حذف مینمایند. حذف این سلولهای آسیبرسان در موشها، نه تنها طول عمر، بلکه «طول سلامت» را افزایش داده و شروع بیماریهای مرتبط با پیری مانند آب مروارید، پوکی استخوان و تحلیل عضلات را به تاخیر انداخته است. چندین داروی سنولیتیک در حال حاضر در مرحله آزمایشات بالینی اولیه روی انسان هستند.
حوزه دیگر، تحقیق بر روی مولکولی به نام «نیکوتینامید آدنین دینوکلئوتید» (NAD+) است. سطح این مولکول کلیدی که در تولید انرژی و ترمیم DNA نقش دارد، با افزایش سن به شدت کاهش مییابد. پیشمادههای NAD+ مانند «نیکوتینامید مونونوکلئوتید» (NMN) و «نیکوتینامید ریبوزید» (NR) در مدلهای حیوانی باعث بهبود عملکرد متابولیک، افزایش استقامت فیزیکی و حتی معکوس کردن برخی جنبههای پیری عروقی شدهاند. اگرچه این مکملها امروز به صورت آزاد در دسترس هستند، اما شواهد قطعی از اثرگذاری آنها در انسانهای سالم هنوز در دست نیست و تحقیقات گستردهتری در جریان است.
رژیمهای غذایی خاص نیز در کانون توجه هستند. «کالری محدودی» (CR) یکی از قویترین مداخلات شناخته شده برای افزایش طول عمر در گونههای مختلف است. اما از آنجایی که رژیمهای سخت برای اکثر مردم عملی نیست، دانشمندان در جستجوی «میمتیکهای محدودیت کالری»—یعنی داروهایی که اثرات مفید گرسنگی را بدون نیاز به کمخواری تقلید کنند—هستند. داروی «متفورمین» که دههها برای درمان دیابت استفاده شده، یک کاندیدای پیشرو است. مطالعات اپیدمیولوژیک نشان داده بیماران دیابتی تحت درمان با متفورمین، با وجود بیماری، نسبت به همتایان سالم خود طول عمر بیشتری دارند. آزمایش بزرگ «TAME» قصد دارد تأثیر متفورمین را در به تاخیر انداختن بیماریهای مرتبط با پیری در افراد غیردیابتی بررسی کند.
اما جذابترین و در عین حال بحثبرانگیزترین حوزه، مهندسی ژنتیک و اپیژنتیک است. دانشمندانی مانند «دیوید سینکلر» از دانشگاه هاروارد معتقدند پیری اساساً یک «از دست دادن اطلاعات اپیژنتیک» است—یعنی سلولها هویت خود را فراموش میکنند. تیم او با استفاده از فناوری «برنامهریزی مجدد» توانسته است با فعال کردن موقت چند ژن خاص (عوامل یاماناکا)، سلولهای پیر را به حالتی جوانتر بازگرداند و بینایی آسیبدیده موشهای مسن را بازیابی کند. این رویکرد، اگر ایمن باشد، میتواند به معنای بازنشانی ساعت بیولوژیکی کل بافتها یا حتی کل ارگانیسم باشد.
با این حال، چالشها و پرسشهای اخلاقی عمیقی وجود دارد. اولاً، ایمنی: آیا دستکاری فرآیندهای اساسی پیری میتواند خطر سرطان را افزایش دهد؟ ثانیاً، دسترسی: اگر درمانهای ضدپیری بسیار گران باشند، آیا فقط به نخبگان ثروتمند تعلق میگیرند و نابرابریهای اجتماعی را به شکل دهشتناکی تشدید میکنند؟ ثالثاً، معنایی: اگر طول عمر به شدت افزایش یابد، تأثیر آن بر روان انسان، جامعه، روابط، منابع سیاره و مفهوم زندگی چیست؟ آیا ما واقعاً میخواهیم برای همیشه زندگی کنیم؟
هدف اصلی پژوهشگران برجسته این حوزه امروزه نه «جاودانگی»، بلکه «طول سلامت» است—افزایش تعداد سالهای زندگی همراه با سلامت و نشاط، و فشرده کردن دوره بیماری و ناتوانی در پایان عمر. این به معنای زندگی ۱۵۰ ساله با ۱۲۰ سال سلامت مطلوب است، نه زندهماندن در رنج. علم ضدپیری در نهایت در پی درمان ریشهای بیماریهایی است که با افزایش سن ظاهر میشوند: سرطان، آلزایمر، بیماری قلبی، دیابت و آرتروز.
بنابراین، آیا کلید جاودانگی یافته شده است؟ خیر، کلید واحدی وجود ندارد. پیری یک فرآیند پیچیده و چندعاملی است. اما برای اولین بار در تاریخ، ما ابزارهای علمی برای هدف قرار دادن مکانیسمهای آن را در اختیار داریم. آینده به احتمال زیاد شاهد ترکیبی از مداخلات—داروهای سنولیتیک، تقویتکنندههای NAD+، رژیمهای غذایی بهینه، و درمانهای ژنتیکی شخصیشده—خواهد بود که با هم برای به تاخیر انداختن پیری همکاری میکنند. انقلاب ضدپیری در مراحل اولیه خود است، اما سرعتی سریع دارد. دهه آینده ممکن است شاهد باشیم که «پیری» به عنوان یک نشانه برای درمان، به مطب پزشکان وارد شود. این ممکن است بزرگترین دستاورد علم پزشکی در تاریخ بشر باشد.
